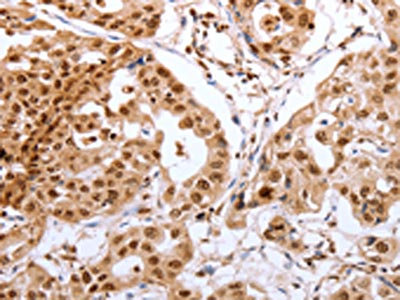

PTTG1 Antibody
-
中文名稱:PTTG1兔多克隆抗體
-
貨號:CSB-PA989924
-
規格:¥1100
-
圖片:
-
The image on the left is immunohistochemistry of paraffin-embedded Human breast cancer tissue using CSB-PA989924(PTTG1 Antibody) at dilution 1/60, on the right is treated with synthetic peptide. (Original magnification: ×200)
-
The image on the left is immunohistochemistry of paraffin-embedded Human lung cancer tissue using CSB-PA989924(PTTG1 Antibody) at dilution 1/60, on the right is treated with synthetic peptide. (Original magnification: ×200)
-
-
其他:
產品詳情
-
Uniprot No.:
-
基因名:
-
別名:AW555095 antibody; C87862 antibody; Cut2 antibody; EAP 1 antibody; EAP1 antibody; ESP1 associated protein 1 antibody; Esp1-associated protein antibody; hPTTG antibody; MGC126883 antibody; MGC138276 antibody; Pds1 antibody; Pituitary tumor transforming 1 antibody; Pituitary tumor transforming protein 1 antibody; Pituitary tumor-transforming 1; isoform CRA_a antibody; Pituitary tumor-transforming 1; isoform CRA_b antibody; Pituitary tumor-transforming gene 1 antibody; Pituitary tumor-transforming gene 1 protein antibody; PTTG 1 antibody; PTTG antibody; PTTG1 antibody; PTTG1 protein antibody; PTTG1_HUMAN antibody; Pttg3 antibody; Securin antibody; Tumor transforming 1 antibody; Tumor transforming protein 1 antibody; Tumor-transforming protein 1 antibody; TUTR 1 antibody; TUTR1 antibody
-
宿主:Rabbit
-
反應種屬:Human
-
免疫原:Synthetic peptide of Human PTTG1
-
免疫原種屬:Homo sapiens (Human)
-
標記方式:Non-conjugated
-
抗體亞型:IgG
-
純化方式:Antigen affinity purification
-
濃度:It differs from different batches. Please contact us to confirm it.
-
保存緩沖液:-20°C, pH7.4 PBS, 0.05% NaN3, 40% Glycerol
-
產品提供形式:Liquid
-
應用范圍:ELISA,IHC
-
推薦稀釋比:
Application Recommended Dilution ELISA 1:2000-1:10000 IHC 1:100-1:300 -
Protocols:
-
儲存條件:Upon receipt, store at -20°C or -80°C. Avoid repeated freeze.
-
貨期:Basically, we can dispatch the products out in 1-3 working days after receiving your orders. Delivery time maybe differs from different purchasing way or location, please kindly consult your local distributors for specific delivery time.
-
用途:For Research Use Only. Not for use in diagnostic or therapeutic procedures.
相關產品
靶點詳情
-
功能:Regulatory protein, which plays a central role in chromosome stability, in the p53/TP53 pathway, and DNA repair. Probably acts by blocking the action of key proteins. During the mitosis, it blocks Separase/ESPL1 function, preventing the proteolysis of the cohesin complex and the subsequent segregation of the chromosomes. At the onset of anaphase, it is ubiquitinated, conducting to its destruction and to the liberation of ESPL1. Its function is however not limited to a blocking activity, since it is required to activate ESPL1. Negatively regulates the transcriptional activity and related apoptosis activity of TP53. The negative regulation of TP53 may explain the strong transforming capability of the protein when it is overexpressed. May also play a role in DNA repair via its interaction with Ku, possibly by connecting DNA damage-response pathways with sister chromatid separation.
-
基因功能參考文獻:
- the short form of securin does not influence the expression of MYC transcriptional targets, such as TP53 and IL-8. PMID: 29989583
- Data strongly indicated that PTTG1 is a target gene of miR186 in osteosarcoma (OS) cells and is involved in miR186mediated suppressive effects of OS cells. PMID: 29693191
- Results show that PTTG1 oncoprotein overexpression may modulate cell proliferation-related regulators in myeloid leukemia. PMID: 29649138
- In ACTH-secreting pituitary tumors, IHC staining showed strong cytoplasmic and moderate nucleic PTTG immunoreactivity in 22 of 28 nonrecurrent tumors and in 21 of 27 recurrent tumors but no staining in the 2 normal pituitaries. PTTG was significantly increased in both the nonrecurrent and recurrent groups compared with normal pituitary glands, but there was no difference between the nonrecurrent and recurrent groups. PMID: 29432944
- Smurf1 interacts with and targets Securin, an inhibitor of sister-chromatid separation, for poly-ubiquitination and proteasomal degradation. PMID: 28658604
- PTTG-1 oexpression in meningiomas were correlated with tumor grade and proliferation rate. PMID: 29575197
- Results found that PTTG1 expression was significantly increased in androgen-independent prostate cancer cells and, elucidates that interleukin-6/STAT3 activation can increase PTTG1 expression and, consequently, promote the resistance to androgen deprivation therapy in castration-resistant prostate cancer by inducing EMT and increasing the cancer stem cell population. PMID: 29288516
- we confirmed the oncogenic function of PTTG1 in BC and demonstrated that PTTG1 is a target of miR-146a-3p. PMID: 27893422
- PTTG1 is an independent prognostic factor and acts as an oncogene in colorectal cancer PMID: 28219049
- High PTTG1 expression is associated with aggressive meningiomas. PMID: 26894859
- These results indicate PTTG1 may be a valuable biomarker in ovarian cancer to predict sensitivity to saracatinib, and could form the basis of a targeted prospective saracatinib trial for ovarian cancer. PMID: 27766744
- A relatively stable genome in retinoblastoma tumor cells is maintained by TRb1 and TRb2-mediated PTTG1 inhibition, counteracting Rb-deficiency-related genomic instability. PMID: 28242412
- Findings indicate that PBF and PTTG have a critical role in promoting thyroid cancer that is predictive of poorer patient outcome. PMID: 28504713
- PTTG-mediated FGF2 upregulation is associated with more aggressive tumor features in patients with acromegaly. Also, locally produced estrogen through aromatization might have a role in this phenomenon. PMID: 26578364
- All these suggest that the MAP3K M1P site is a potential interacting partner of MAP3K SH3 domain, which may mediate the intermolecular recognition between hPTTG1 and MAP3K. PMID: 27787230
- that PTTG1 is a novel downstream target gene of androgen receptor and take part in prostate cancer proliferation and metastasis PMID: 27756608
- Knockdown of PTTG1 suppresses the growth and invasion of LAC cells through upregulation of the TGFbeta1/SMAD3 signaling. PMID: 25816405
- PTTG1 is correlated with non-small cell lung cancer (NSCLC) progression and as an independent poor prognostic factor in NSCLC patients. PMID: 27829547
- Our data indicate that securin expression may serve as a strong and independent prognosticator of breast cancer outcome PMID: 26984614
- PTTG1 mRNA expression levels in gastric tumor tissues were significantly higher than in the corresponding adjacent normal gastric mucosa.PTTG1 mRNA and protein expression are independent prognostic factors for gastric cancer patient survival. PMID: 25627474
- Pttg1 may increase BC cell growth through nuclear exclusion of p27, which highlights a novel molecular regulatory machinery in tumorigenesis of BC. PMID: 26824458
- Data show that overexpression of c-myc proto-oncogene protein could prevent the metabolic shift induced by pituitary tumor-transforming gene (PTTG) knockwown. PMID: 26516926
- Report feedback loop between PTTG1 targeting miRNAs, PTTG1 and p53 that promotes pituitary tumorigenesis. PMID: 26320179
- knockdown of PTTG1 increased expression of integrin alpha 4 (ITGA4), ITGA5, and integrin beta 1 (ITGB1); otherwise, RhoA expression was significantly decreased PMID: 26900962
- Data show that pituitary tumor-transforming 1 protein (PTTG1) is over-expressed in multiple myeloma (MM) patients and is associated with poor survival. PMID: 26445238
- Silencing of PTTG could also inhibit tumor growth, invasion, and angiogenesis in vivo. Our data indicated that PTTG might be a potential target for glioma treatment PMID: 25908389
- FoxM1 binds to PTTG1 promoter to enhance PTTG1 transcription, and FoxM1-PTTG1 pathway promotes colorectal cancer migration and invasion PMID: 26264222
- we demonstrated here the inhibitory effect of CACP on the growth of H22 cells in vitro and in vivo, which may be through, at least partly, repression of PTTG1 and then followed by the inactivation of P13/Akt and activation of p38 MARK signaling pathways PMID: 25874498
- PTTG1 enhances HBV replication through suppression of P53. PMID: 26710612
- In peripheral area of testicular seminoma, PTTG1 staining was located in cell nucleus. In central area, staining was more intense in cytoplasm. On the other hand, in embryonal carcinoma, cells had diffuse positive staining, mainly in cytoplasm. PMID: 24754453
- PTTG1 is differentially expressed by benign and malignant pheochromocytoma with low sensitivity; meaning that positive immunohistochemistry result for PTTG1 is of great value to predict malignant behavior of pheochromocytoma PMID: 25871022
- PTTG1 is a marker for proliferative skin diseases associated with cell cycle regulation and may aid in detection of aggressive cancers PMID: 25549700
- Our findings provide novel molecular insights into hPTTG1-induced senescence and identify a novel mechanism by which hPTTG1 promotes metastasis by regulating the senescence-associated microenvironment. PMID: 22789011
- The interaction between TERT and PTTG1 by association of Ku70 might be important for the enhancement of the limited self-renewal activity of MSCs and for understanding the regulatory mechanisms of self-renewal. PMID: 24816985
- This study demonstrated that PTTG was expressed in most of meningioma tissues, and the degree of PTTG immunostaining was variable in the subtypes of tumors PMID: 24908230
- This present meta-analysis suggests that PTTG expression may be associated with tumor invasiveness and microvessel density of pituitary adenomas. PMID: 24594688
- The numbers of migrating cells (51.38 +/- 4.71) in the PTTG siRNA group was obviously lower. PMID: 24377512
- Data indicate that pituitary tumor-transforming gene 1 (PTTG1) was frequently overexpressed in oral squamous cell carcinoma (OSCC) tissues. PMID: 24879625
- PTTG may contribute to the malignant progression of esophageal squamous cell carcinoma (ESCC) and serve as a novel prognostic indicator for patients with ESCC. PMID: 24176776
- our data suggest that PTTG1 promotes the proliferation of prostate cancer cells via the inhibition of SMAD3. SMAD3 thus appears to be a novel therapeutic target for suppressing the growth of prostate cancer. PMID: 24627133
- high Cdc20 and securin immunoexpression identified a patient subgroup with extremely short, on average 2.4 years, breast cancer survival and triple-negative breast cancer subtype. PMID: 24853182
- findings suggest that PTTG1 may act as a major target of miR-655. This study improves our understanding of the mechanisms underlying ESCC pathogenesis PMID: 24314023
- No TTF1 or EAP1 germline mutations were associated with central pubertal disorders. TTF1 and EAP1 may affect puberty by changing expression in response to other members of puberty-associated gene networks PMID: 24051510
- STAT3 induces PTTG expression to facilitate tumor growth and metastasis. PMID: 23416975
- KLF6 directly binds and represses PTTG1 expression during induction of myeloid differentiation. PMID: 23977008
- The expression of hPTTG1 was correlated with differentiation levels, clinical classification and lymph node metastasis, but did not correlate with gender, age or pathological types. PMID: 23128677
- Overexpression of PTTG1, which encodes securin, a negative regulator of p53, was identified as a marker of poor survival in adrenocortical carcinoma. PMID: 24238056
- These results define hPTTG as having a central role in thyroid autocrine signaling mechanisms via growth factors, with profound implications for promotion of transformed cell growth. PMID: 23867215
- Enhanced expression of PTTG1 in the psoriatic epidermis may result in aberrant regulation of the cell cycle and impaired differentiation via the interplay between PTTG1 and TNF-alpha. PMID: 23677169
- This study identified both PTTG1 and miR-186 as potential anti-invasion targets for therapeutic intervention in non-small cell lung cancer . PMID: 23671127
顯示更多
收起更多
-
亞細胞定位:Cytoplasm. Nucleus.
-
蛋白家族:Securin family
-
組織特異性:Expressed at low level in most tissues, except in adult testis, where it is highly expressed. Overexpressed in many patients suffering from pituitary adenomas, primary epithelial neoplasias, and esophageal cancer.
-
數據庫鏈接:
Most popular with customers
-
-
YWHAB Recombinant Monoclonal Antibody
Applications: ELISA, WB, IHC, IF, FC
Species Reactivity: Human, Mouse, Rat
-
Phospho-YAP1 (S127) Recombinant Monoclonal Antibody
Applications: ELISA, WB, IHC
Species Reactivity: Human
-
-
-
-
-